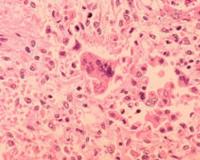

Медики: в Санкт-Петербурге возникла серьезная ситуация заражения корью
13.03.2014 23:57 / Общество / Прочли: 6699 человек
Медики Санкт-Петербурга активно обсуждают тревожную ситуацию, основная причина которой – кор. Как эпидемическое заболевание, информирует медицинский новостной портал MEDdaily, ссылаясь на "РБК".
Дело в том, что этом году зафиксированный уровень заболеваемости стал выше прошлогодних показателей. На протяжении последних трех месяцев в Санкт-Петербурге зафиксировано 16 случаев заболевания кори, в то время как за весь прошлогодний период всего лишь 15.
О заражении кори в северной столице известно, что она носит завозной характер, поскольку пришла из иных регионов. Кстати, это заболевание характерно Дагестану, Чеченской Республике, Кабардино-Балкарии, Ставропольскому и Краснодарскому краю. В основном страдают взрослые. Как правило, жертва инфекции – категория людей, которая не проходила вакцинацию.
Кстати, корь активна во всем мире на протяжении многих лет. Страны Европейского региона страдают этим инфекционным заболеванием начиная с конца 2009 года. За период 2013 года в Европе зафиксировано более 26000 случаев заболевания корью. Крупные вспышки зафиксированы в Грузии (7500 заболевших), не менее низкое показатели в Турции (7100 случаев), в Украине, кстати меньше - 2200 случаев, в Германии лишь более 1000 пострадавших, в то время как в Британии 1900 больных.
В прошлом году в России рост заболеваемости корью на увеличился 10,2% по сравнению с предыдущим годом.
Корь – инфекционное заболевание, чрезвычайно опасное и заразное. Достаточно легко передается воздухом. Заболевший страдает лихорадкой, у него воспаляются слизистые верхних дыхательных путей и возможны высыпания на коже.
Эффективнейший метод борьбы с корью - вакцина, защищающая от заболевания в 95% случаях.
Текст:
Т. Сокот

Материалы
сайта могут содержать информацию, не подлежащую просмотру лицам младше 18
лет








